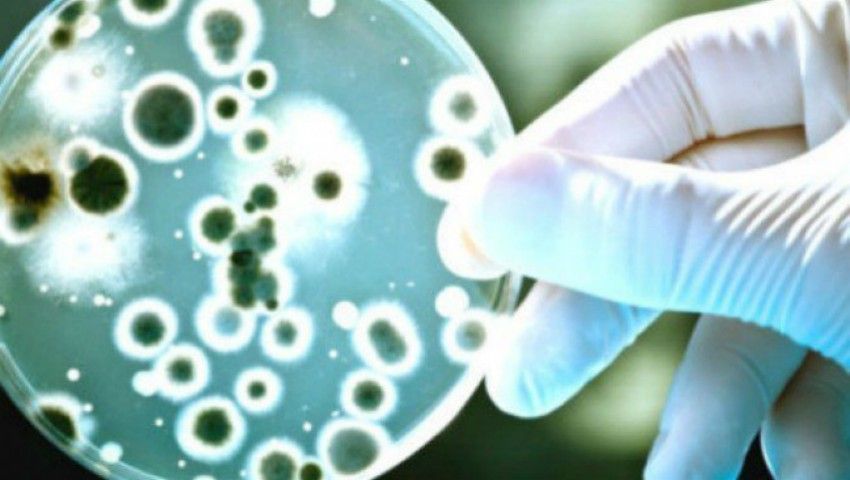

România
Liderul Grupului parlamentar Uniți pentru România, Răzvan Mirel Chiriță, a declarat marți, după consultările de la Cotroceni cu președintele Nicușor Dan, că formațiunea sa îl propune pentru funcția de premier pe Victor Ponta, argumentând că acesta are o experiență guvernamentală și ar putea fi un liant pentru a se ajunge la un consens.
România
Președinta Partidului Oamenilor Tineri, Anamaria Gavrilă, a anunțat marți, după consultările de la Palatul Cotroceni, că parlamentarii POT susțin o formulă de guvernare pro-occidentală, pro-americană.
România
Președinta SOS România, Diana Șoșoacă, a declarat, marți, după consultările de la Cotroceni, că i-a spus președintelui Nicușor Dan că își dorește ca un program de guvernare să fie prezentat la Parlament cu cel puțin 48 de ore înainte.
România
Liderul Grupului Minorităților Naționale din Camera Deputaților, Varujan Pambuccian, estimează că viitorul Guvern va fi unul minoritar.
Local
Instanța anulează definitiv certificatul de urbanism și autorizația de construire care au permis dezvoltarea proiectului de la fostul Antrepozit Andrényi, de pe 6 Vânători.
România
Președintele UDMR, Kelemen Hunor, a declarat, marți, la finalul consultărilor cu președintele Nicușor Dan, că există două variante de guvern minoritar, o a treia variantă fiind un guvern „cu o majoritate foarte subțire”. Au existat întrebări legate de o posibilă sesiune extraordinară, cum și când ar funcționa - la început de iulie sau mai târziu.
România
USR nu va putea să susțină un guvern din care face parte PSD, a afirmat, marți, președintele USR, Dominic Fritz, după consultările de la Cotroceni cu președintele Nicușor Dan.